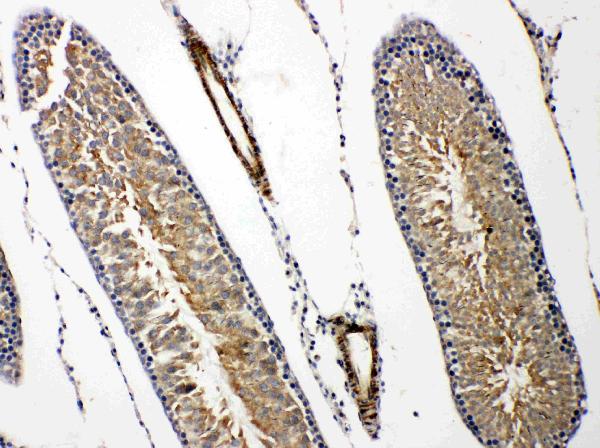

Anti-PRLR antibody, PA2087, IHC(P) IHC(P): Human Mammary Cancer Tissue
Anti-Prolactin Receptor/PRLR Antibody Picoband(r)
PA2087-DYLIGHT550
ApplicationsWestern Blot, ImmunoHistoChemistry
Product group Antibodies
ReactivityHamster, Human, Mouse, Rat
TargetPrlr
Overview
- SupplierBoster Bio
- Product NameAnti-Prolactin Receptor/PRLR Antibody Picoband(r)
- Delivery Days Customer9
- Antibody SpecificityNo cross reactivity with other proteins.
- Application Supplier NoteTested Species: In-house tested species with positive results. Predicted Species: Species predicted to be fit for the product based on sequence similarities. By Heat: Boiling the paraffin sections in 10mM citrate buffer, pH6.0, for 20mins is required for the staining of formalin/paraffin sections. Other applications have not been tested. Optimal dilutions should be determined by end users.
- ApplicationsWestern Blot, ImmunoHistoChemistry
- CertificationResearch Use Only
- ClonalityPolyclonal
- Concentration500 ug/ml
- ConjugateDyLight 550
- Gene ID19116
- Target namePrlr
- Target descriptionprolactin receptor
- Target synonymsAI987712; Pr; Pr-1; Pr-3; PRL-R; Prlr-rs1; prolactin receptor; prolactin receptor related sequence 1
- HostRabbit
- IsotypeIgG
- Protein IDQ08501
- Protein NameProlactin receptor
- Scientific DescriptionBoster Bio Anti-Prolactin Receptor/PRLR Antibody catalog # PA2087. Tested in IHC, WB applications. This antibody reacts with Human, Mouse, Rat. The brand Picoband indicates this is a premium antibody that guarantees superior quality, high affinity, and strong signals with minimal background in Western blot applications. Only our best-performing antibodies are designated as Picoband, ensuring unmatched performance.
- ReactivityHamster, Human, Mouse, Rat
- Storage Instruction-20°C,2°C to 8°C
- UNSPSC12352203